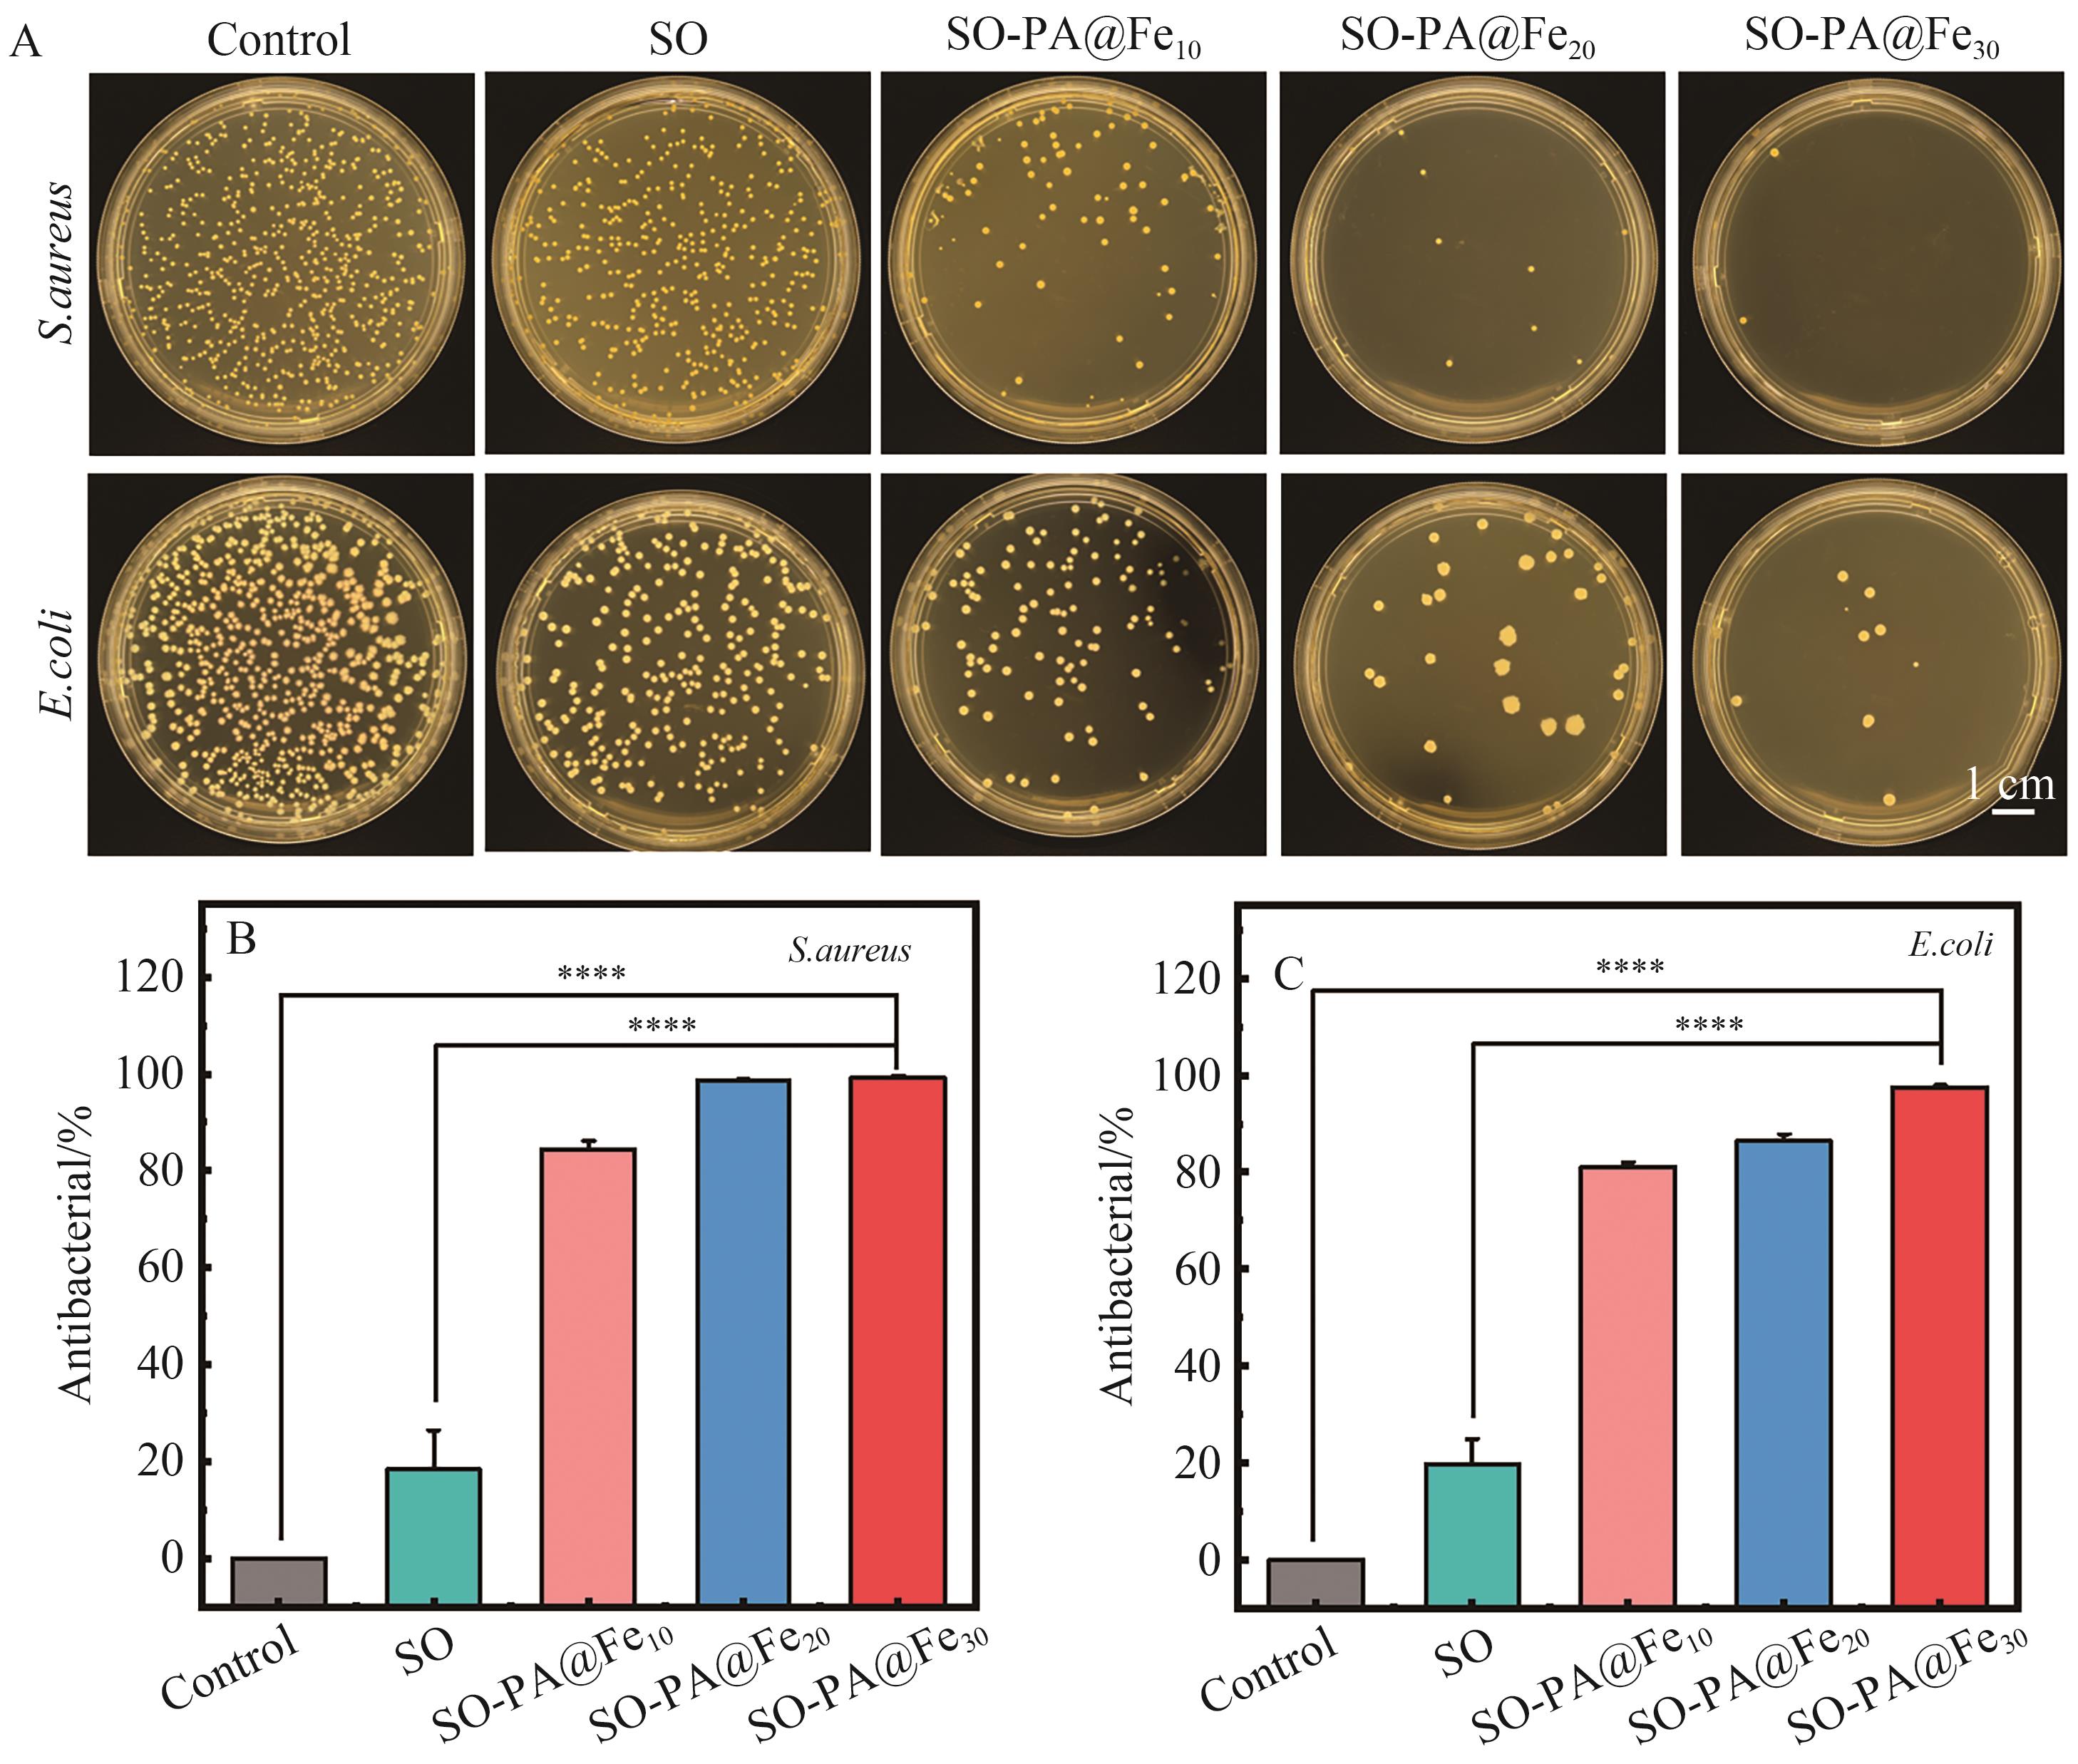

Chinese Journal of Applied Chemistry ›› 2025, Vol. 42 ›› Issue (10): 1349-1360.DOI: 10.19894/j.issn.1000-0518.250063
• Full Papers • Previous Articles Next Articles
Antibacterial, Antioxidant Polysaccharide-Based Hemostatic Sponge for Nasal Tamponade and Hemostasis
Li-Yu SUN1,2, Chuan-Yu GUO1,2, Mei-Lin CHEN1,2, Hao-Zheng WANG1( ), Qiang SHI1(
), Qiang SHI1( )
)
- 1.State Key Laboratory of Polymer Science and Technology,Changchun Institute of Applied Chemistry,Chinese Academy of Sciences,Changchun 130022,China
2.School of Applied Chemistry and Engineering,University of Science and Technology of China,Hefei 230026,China
-
Received:2025-02-21Accepted:2025-07-18Published:2025-10-01Online:2025-10-29 -
Contact:Hao-Zheng WANG,Qiang SHI -
About author:hzwang@ciac.ac.cn
shiqiang@ciac.ac.cn
-
Supported by:Jilin Provincial Scientific and Technological Development Program(20220401088YY);the National Natural Science Foundation of China(52061135202);Changchun Scientific and Technological Development Program(24GXYSZZ19)
CLC Number:
Cite this article
Li-Yu SUN, Chuan-Yu GUO, Mei-Lin CHEN, Hao-Zheng WANG, Qiang SHI. Antibacterial, Antioxidant Polysaccharide-Based Hemostatic Sponge for Nasal Tamponade and Hemostasis[J]. Chinese Journal of Applied Chemistry, 2025, 42(10): 1349-1360.
share this article
Add to citation manager EndNote|Ris|BibTeX
URL: http://yyhx.ciac.jl.cn/EN/10.19894/j.issn.1000-0518.250063

Fig.2 FT-IR (A), XPS full (B) and N1s spectra (C) of SO-PA@Fe10 sponge; (D) SEM image of sponge with various PA@Fe ratios; (E) The pore size distribution of different sponges; (F) EDS image of SO-PA@Fe10 sponge

Fig.3 (A) The porosity of sponge with various PA@Fe volume fraction; (B) Digital photos of sponge before and after water absorption, from left to right are SO, SO-PA@Fe10, the SO-PA@Fe20 and SO-PA@Fe30 sponge; (C) The expansion rate of sponge with various PA@Fe volume fraction after soaking for 1 and 10 min; (D) The degradation rate of sponge with various PA@Fe volume fraction; (E) The compressive strength of sponge; (F) Stress-strain curves of sponge
Fig.5 (A) Bacteriostatic effect of different PA@Fe volume fraction of sponge on Staphylococcus aureus and Escherichia coli; (B) Antibacterial rate of sponge against Staphylococcus aureus; (C) Antibacterial rate of sponge against Escherichia coli

Fig.6 (A) The viability of L929 mouse fibroblasts after 24 and 48 h; (B) The vitality of HUVEC endothelial cells after 24 and 48 h; (C) Cell morphology of L929 mouse fibroblasts stained with dye; (D) Sponge hemolysis test

Fig.7 (A) Measurement of whole blood coagulation index in vitro; (B) Photos of sponge blood absorption ability tests at different time points; (C) Sponge blood absorption rate
| [1] | SEIKALY H. Epistaxis[J]. New Engl J Med, 2021, 384(10): 944-951. |
| [2] | KASLE D A, FUJITA K, MANES R P. Review of clinical practice guideline: nosebleed (epistaxis)[J]. JAMA Surg, 2021, 156(10): 974-975. |
| [3] | CABRERA-RAMÍREZ M S, DOMÍNGUEZ-SOSA M S, BORKOSKI-BARREIRO S A, et al. Analysis and results of endoscopic sinus surgery in chronic rhinosinusitis with polyps[J]. Acta Otorrinolaringol Esp, 2017, 68(2): 80-85. |
| [4] | CHOU T W, CHEN P S, LIN H C, et al. Multiple analyses of factors related to complications in endoscopic sinus surgery[J]. J Chin Med Association, 2016, 79(2): 88-92. |
| [5] | HADDADY-ABIANEH S, RAJABPOUR A A, SANATKARFAR M, et al. The hemostatic effect of desmopressin on bleeding as a nasal spray in open septorhinoplasty[J]. Aesthetic Plast Surg, 2019, 43(6): 1603-1606. |
| [6] | ELOY P, ANDREWS P, POIRRIER A L. Postoperative care in endoscopic sinus surgery: a critical review[J]. Curr Opin Otolaryngol Head Neck Surg, 2017, 25(1): 35-42. |
| [7] | MASSEY C J, SINGH A. Advances in absorbable biomaterials and nasal packing[J]. Otolaryngol Clin North Am, 2017, 50(3): 545-563. |
| [8] | QI C, XU L, DENG Y, et al. Sericin hydrogels promote skin wound healing with effective regeneration of hair follicles and sebaceous glands after complete loss of epidermis and dermis[J]. Biomater Sci, 2018, 6(11): 2859-2870. |
| [9] | IQBAL I Z, JONES G H, DAWE N, et al. Intranasal packs and haemostatic agents for the management of adult epistaxis: systematic review[J]. J Laryngol Otol, 2017, 131(12): 1065-1092. |
| [10] | SELVARAJAH J, MH BUSRA M F, BIN SAIM A, et al. Development and physicochemical analysis of genipin-crosslinked gelatine sponge as a potential resorbable nasal pack[J]. J Biomater Sci Polym Ed, 2020, 31(13): 1722-1740. |
| [11] | HAMLETT K E L, YANEZA M M C, GRIMMOND N. Epistaxis[J]. Surgery (Oxf), 2021, 39(9): 577-590. |
| [12] | GIOACCHINI F M, ALICANDRI-CIUFELLI M, KALECI S, et al. The role of antibiotic therapy and nasal packing in septoplasty[J]. Eur Arch Otorhinolaryngol, 2014, 271(5): 879-886. |
| [13] | LANGE J L, PEEDEN E H, STRINGER S P. Are prophylactic systemic antibiotics necessary with nasal packing? a systematic review[J]. Am J Rhinol Allergy, 2017, 31(4): 240-247. |
| [14] | NEPAL A, TRAN H D N, NGUYEN N T, et al. Advances in haemostatic sponges: characteristics and the underlying mechanisms for rapid haemostasis[J]. Bioact Mater, 2023, 27: 231-256. |
| [15] | BAN K A, MINEI J P, LARONGA C, et al. American college of surgeons and surgical infection society: surgical site infection guidelines[J]. J Am Coll Surg, 2017, 224(1): 59-74. |
| [16] | ZHU L, ZHANG S, ZHANG H, et al. Polysaccharides composite materials for rapid hemostasis[J]. J Drug Deliv Sci Technol, 2021, 66: 102890. |
| [17] | CAO S, XU G, LI Q, et al. Double crosslinking chitosan sponge with antibacterial and hemostatic properties for accelerating wound repair[J]. Compos B Eng, 2022, 234: 109746. |
| [18] | LI M, WANG H, HU J, et al. Smart hydrogels with antibacterial properties built from all natural building blocks[J]. Chem Mater, 2019, 31(18): 7678-7685. |
| [19] | WANG Y H, LI W H, DU G H. Natural small molecule drugs from plants[M]. Germany: Springer Group, 2018: 115-120. |
| [20] | DU Y, BAI Y, LANG S, et al. Gelatin sponges with a uniform interoperable pore structure and biodegradability for liver injury hemostasis and tissue regeneration[J]. Biomacromolecules, 2023, 24(11): 5313-5327. |
| [21] | DONG L, CHONG W, ZENG X, et al. The synthesis of a rhodamine B schiff-base chemosensor and recognition properties for Fe3+ in neutral ethanol aqueous solution[J]. Sens Actuators B: Chem, 2010, 145(1): 433-437. |
| [22] | LIANG Y, LI Z, HUANG Y, et al. Dual-dynamic-bond cross-linked antibacterial adhesive hydrogel sealants with on-demand removability for post-wound-closure and infected wound healing[J]. ACS Nano, 2021, 15(4): 7078-7093. |
| [23] | ZHAO J, ZHU H, XU T, et al. Self-healing oxidized dextran/sodium alginate hydrogel dressing with hemostatic activity speeds up wound healing in burn injuries[J]. ACS Appl Mater Interfaces, 2025, 17(2): 2940-2951. |
| [24] | PANDIT A H, MAZUMDAR N, AHMAD S. Periodate oxidized hyaluronic acid-based hydrogel scaffolds for tissue engineering applications[J]. Int J Biol Macromol, 2019, 137: 853-869. |
| [25] | LI G, QUAN K, LIANG Y, et al. Graphene-montmorillonite composite sponge for safe and effective hemostasis[J]. ACS Appl Mater Interfaces, 2016, 8(51): 35071-35080. |
| [26] | CHENG F, LIU C, WEI X, et al. Preparation and characterization of 2,2,6,6-tetramethylpiperidine-1-oxyl (tempo)-oxidized cellulose nanocrystal/alginate biodegradable composite dressing for hemostasis applications[J]. ACS Sustainable Chem Eng, 2017, 5(5): 3819-3828. |
| [27] | ZHANG Y, GUAN J, WU J, et al. N-Alkylated chitosan/graphene oxide porous sponge for rapid and effective hemostasis in emergency situations[J]. Carbohydr Polym, 2019, 219: 405-413. |
| [28] | KOHANSKI M A, DWYER D J, HAYETE B, et al. A common mechanism of cellular death induced by bactericidal antibiotics[J]. Cell, 2007, 130(5): 797-810. |
| [29] | QU J, ZHAO X, LIANG Y, et al. Antibacterial adhesive injectable hydrogels with rapid self-healing, extensibility and compressibility as wound dressing for joints skin wound healing[J]. Biomaterials, 2018, 183: 185-199. |
| [30] | LI S, YU Y, CHEN J, et al. Evaluation of the antibacterial effects and mechanism of action of protocatechualdehyde against ralstonia solanacearum[J]. Molecules, 2016, 21(6): 754. |
| [1] | Jia-Tian YANG, Yu MIAO, Meng-Ting WEI, Ning WANG, Yi-Qi LI, Yuan CHEN, Feng QIN, Hua-Yu HU. Preparation Process and Water-Reducing Performance of Carboxymethyl- β -Cyclodextrin by Mechanically Activated Dry Method [J]. Chinese Journal of Applied Chemistry, 2025, 42(4): 499-510. |
| [2] | Ju-Ying XIAO, Xia ZHAO, Yuan LIN, Zhao-Hui SU. Preparation and Investigation of Functional PEGylated Chitosan Nanoparticles [J]. Chinese Journal of Applied Chemistry, 2025, 42(3): 386-395. |
| [3] | Xiang HE, Jing WANG, Zi-Xin XING, Zhe-Peng LIU, Shu-Yi WANG, Li-Rong NIE. Preparation and Wound Healing Properties of Indomethacin-Loaded Nanofibers [J]. Chinese Journal of Applied Chemistry, 2024, 41(11): 1629-1638. |
| [4] | Xing-Yi LIANG, Ya LI, Jing-Tian XUN, Wei-Wei ZHANG, Chang-Zi JIN, Rui WANG, Dan QIU, Yu-Peng HE. Preparation of Regenerated Cellulose Microspheres and Their Adsorption of Methylene Blue and Loading of Folic Acid [J]. Chinese Journal of Applied Chemistry, 2024, 41(10): 1445-1456. |
| [5] | Ming-Yu LIU, Jing-Wei DAI. Hydrogels: Exploring Innovative Materials for the Future of Medicine [J]. Chinese Journal of Applied Chemistry, 2024, 41(10): 1511-1518. |
| [6] | Tian-He GAO, Li-Juan YAN, Ming-Qing CHEN, Wei-Fu DONG, Dong-Jian SHI. Preparation and Properties of Antibacterial Composite Films with High Loading of Citral [J]. Chinese Journal of Applied Chemistry, 2024, 41(9): 1284-1296. |
| [7] | Zhi LU, Chun-Yan WANG, Hong-Yu SHI, Jun-Ling ZHU. Preparation of Sorghum Polyphenol Microcapsules and Its Correlation with Physical and Chemical Properties [J]. Chinese Journal of Applied Chemistry, 2024, 41(8): 1146-1153. |
| [8] | Ze-Hao JIN, Li-Li WANG, Rui HOU, Shou-Kang HU. Manganese Dioxide Nanorods-Doped Cellulose Composite Film for Piezoelectric Nanogenerators [J]. Chinese Journal of Applied Chemistry, 2024, 41(6): 851-860. |
| [9] | Shou-Cun ZHANG, Xue-Yin YAN, Yang-Hua SONG, Zhuo-Min LI. Preparation of CO2 Stimulus-Responsive Hydrogel and Its Application in Protein Separation [J]. Chinese Journal of Applied Chemistry, 2024, 41(6): 870-877. |
| [10] | Jun-Peng GAO, Ting-Ting WANG, XU Hu, Shi-Cai JIANG, Hua DENG, Bao-Yan ZHANG. Preparation and Properties of Fiber Reinforced Composite Materials with Space Radiation Resistance [J]. Chinese Journal of Applied Chemistry, 2024, 41(6): 899-905. |
| [11] | Xin-Xing LIN, Na LI, Zu-Wu TANG, Hui-Min YANG, Long-Yu LI, Hui WU. Research Progress of Liquid Marble Constructed by Various Particles [J]. Chinese Journal of Applied Chemistry, 2024, 41(3): 377-390. |
| [12] | Huai-Li ZHENG, Wei LIU, Man-Li SUN. Research Progress of Natural Polymer Flocculants with Antibacterial Function [J]. Chinese Journal of Applied Chemistry, 2024, 41(2): 177-189. |
| [13] | Wei-Na HAO, Chao ZHOU, Hai-Ping DI, Lin-Hong DENG. Preparation and Characterization of Graphene Oxide-Hyaluronic Acid-Polyethylene Glycol Composite Supramolecular Hydrogel [J]. Chinese Journal of Applied Chemistry, 2023, 40(12): 1672-1681. |
| [14] | Qi-Yun JIANG, Jun-Jie CHEN, Hao CHEN, Zhi-Qiang WU, Chun-Hui SHEN, Shan-Jun GAO. Preparation and Properties of Organic Zirconium Crosslinked Konjac Glucomannan Gel [J]. Chinese Journal of Applied Chemistry, 2023, 40(10): 1437-1447. |
| [15] | Jia-Hui LIU, Bai-Chao AN, Qiu-Yan YAN, Shi-Fang LUAN. Preparation and Properties of Mussel-Inspired Antibacterial Bone Adhesive [J]. Chinese Journal of Applied Chemistry, 2023, 40(9): 1258-1266. |
| Viewed | ||||||
|
Full text |
|
|||||
|
Abstract |
|
|||||

